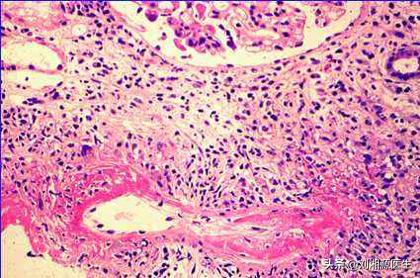
「免疫相关不良妊娠答疑解惑40」——系统性血管炎

作者:
孙笑丛(大同第二医院)
金银姬、刘湘源(北京大学第三医院)
李胜光(北大国际医院)
姜林娣(复旦大学附属中山医院)
付锦华(山东青岛锦华医院)
1.什么是系统性血管炎?
答:系统性血管炎是一组原因不明、以非感染性炎症和坏死性血管炎(见图1)为基本病理改变的结缔组织病。一般而言,不同类型血管炎中,其临床表现常因受累血管的大小、类型和部位的不同而各异。在临床上常表现为发热、乏力、皮肤损害、关节炎、多系统损害和多脏器功能衰竭。
图1 病理显示坏死性血管炎
2.系统性血管炎在我国常见吗?
答:系统性血管炎有二十余种之多,包括大动脉炎、白塞病、结节性多动脉炎和ANCA相关性血管炎等等,不同的疾病其发病率也不同。总的来说,该组疾病的整体发病并不少见,在西方国家其发病率高于系统性红斑狼疮,与类风湿关节炎相近,在我国发病率也不低,各个年龄阶段均有发生,如,大动脉炎主要见于青年女性,而巨细胞动脉炎和ANCA相关性血管炎则主要累及中老年人,但目前还没有全国性的流行病学调查资料。
3.系统性血管炎是怎么发生的?
答:各类系统性血管炎中大部分的确切病因尚不明确,目前认为存在感染原对血管的直接损害和免疫异常介导的炎症反应。
1) 某些病原体的感染(细菌、病毒、螺旋体、真菌及立克次体等)或其代谢产物直接或间接损害血管引起血管炎。
2) 免疫异常方面有:
- 免疫复合物介导,即外源性抗原刺激机体发生异常免疫反应,产生的大量抗原抗体免疫复合物,激活体液和细胞免疫及炎症介质系统,导致炎细胞聚集、血管壁坏死。这种发病机制可见于过敏性血管炎、IgA血管炎、冷球蛋白血症、乙肝病毒相关性血管炎和抗肾小球基底膜病;
- 自身抗体直接介导,即抗血管内皮细胞和毛细血管内膜的自身抗体可与抗原直接结合,形成原位免疫复合物,激活补体,引起血管炎;
- 抗中性粒细胞胞浆抗体介导,即抗中性粒细胞胞浆抗体可与中性粒细胞及单核细胞反应,激活炎症介质,导致血管炎;
- T细胞介导,即T细胞黏附并穿过血管内皮进入肌层,导致血管炎病变;
3)基因异常,目前认为,HLA-B51与白塞病的发病相关,HLA-B52可能与大动脉炎相关。
4)药物因素,丙硫氧嘧啶、肼苯达嗪、青霉胺和米诺环素等可能诱导ANCA相关性血管炎。
5)肿瘤、血液系统疾病等所致。

4.系统性血管炎是否会遗传?是遗传男孩还是女孩?
答:系统性血管炎的原因目前还不清楚,有部分疾病可能存在一定的遗传因素,但它们并不是我们通常说的遗传性疾病,据调查,只有不到10%的患者有家族聚集倾向,但是目前并不清楚遗传因素与孩子的性别是否有关。
5.系统性血管炎能否治愈?
答:系统性血管炎是风湿科或风湿免疫科,甚至是大内科中最难诊断及治疗的疑难病和复杂病,目前已知的免疫相关的血管炎病种中,仍然是无法治愈的,但是,大部分患者经过早诊断和积极治疗均可得到较好的控制,当然,控制到何种程度与就诊时的疾病严重程度和疾病种类有很大关系。我们鼓励广大血管炎的患者患病后要及早就医、早诊断、早治疗。
6.系统性血管炎会导致死亡吗?
答:系统性血管炎是一组原因未明,临床表现复杂,病情凶险而多样的疾病,如果诊治不及时,可致残,甚至死亡。死亡的原因主要包括以下几个方面,
1)感染,这是本组疾病发病后第一年死亡的主要原因(占48%),也是整个病程中死亡的主要原因,尤其在疾病的诱导缓解阶段,使用大剂量糖皮质激素和环磷酰胺等免疫*制剂抑**,包括这些免疫*制剂抑**引起的中性粒细胞和淋巴细胞数减少是感染的高危因素;
2)心、脑血管事件(占26%),与一般人群相比,本组疾病罹患心、脑血管疾病的风险增高2~4倍,卒中也常见;
3)肿瘤(占22%),有研究显示,长期应用环磷酰胺的患者,10年和15年膀胱癌的发生率分别是5%和16%,这可能与环磷酰胺的累积剂量有关。
7.系统性血管炎有哪些分类方法,具体有哪些疾病?
答:1952 年 Zeek 首先提出血管炎的分类方法,将血管炎分为过敏性动脉炎、过敏性肉芽肿性动脉炎、风湿性动脉炎、结节性动脉周围炎和颞动脉炎 5 类,该分类法粗糙,反映了当时人们对血管炎病的粗浅认识,现已被淘汰。很长一段时间里临床常用的是1994年在系统性血管炎Chapel Hill 共识会议上发布的分类标准。该标准完全按照受累血管的大小,分为大血管炎、中等血管炎和小血管炎。其中累及大、中血管的包括大动脉炎和颞动脉炎(巨细胞动脉炎);累及中、小血管的包括结节性多动脉炎、川崎病和孤立性中枢神经系统性血管炎;累及小血管的包括肉芽肿性多血管炎、变应性肉芽肿性多血管炎、显微镜下多血管炎、过敏性紫癜和皮肤白细胞破碎性血管炎。这一方法便于临床应用,缺陷是未分原发性和继发性,另外,有很多明确的血管炎,如白塞病、伯格病、科根综合征等未被收入其中。直到2012 年的第二次Chapel Hill 血管炎的共识会议上提出了最新的分类方法:
1)大血管炎,包括大动脉炎和巨细胞动脉炎;
2)中等血管炎,包括结节性多动脉炎和川崎病;
3)小血管炎,根据血管壁上免疫复合物沉积的多寡分为 ANCA 相关性血管炎和免疫复合物性小血管炎,其中ANCA 相关性血管炎又分为显微镜下多血管炎、肉芽肿性多血管炎和嗜酸性肉芽肿性多血管炎。免疫复合物性小血管炎一般指原发性(继发性归为其他类别),包括抗肾小球基底膜病、冷球蛋白血症性血管炎、IgA 血管炎和低补体血症性*麻疹荨**性血管炎;
4)变异性血管炎:包括白塞病和科根综合征;
5)单器官性血管炎:必须除外为系统性血管炎累及该器官/系统所致病变;
6)与系统性疾病相关及与可能的病因相关的血管炎,均属于继发性血管炎,其中可能相关的因素包括结缔组织病、肿瘤、感染性疾病、淋巴细胞增殖性疾病、骨髓异常增生综合征、IgG4 相关性疾病及某些药物等。

图2 系统性血管炎不同血管的受累
8.与1994 Chapel Hill 会议标准相比,2012 年Chapel Hill 会议提出的血管炎分类方法有哪些变化?
答:1)除大血管炎、中血管炎、小血管炎以外,2012年的Chapel Hill血管炎共识会议增加了变异性血管炎、单器官性血管炎、与系统性疾病相关的血管炎及与可能的病因相关的血管炎四大类;
2)将某些以人名命名的疾病更名为基于疾病特点或病因的命名,如,韦格纳肉芽肿更名为肉芽肿性多血管炎,再如,Churg-Strauss 综合征更名为嗜酸性肉芽肿性多血管炎,最后,将过敏性紫癜更名为 IgA 血管炎;
3)将小血管炎细分为两大类:ANCA 相关性血管炎和免疫复合物性小血管炎,阐述了二者之间在疾病特点、本质、病因等方面的异同点。另外对于某些疾病的具体分类也有所调整,如将小血管炎中的皮肤白细胞破碎性血管炎归入了单器官性血管炎中,新加入了低补体血症性*麻疹荨**性血管炎。
9.2012 年Chapel Hill 会议提出的系统性血管炎分类方法有哪些有优缺点?
答:优点:
1)对 ANCA 的认识明显更为深入,ANCA 作为目前发现的唯一对血管炎具有诊断意义的血清学标志物,在标准中被置于空前重要的地位。如临床表现相似的结节性多动脉炎与ANCA相关性血管炎,ANCA 阳性与否往往是及其重要的,甚至是唯一的鉴别点。
2)分类更为完整、合理,增加了四大类血管炎(见问题7),在临床工作中的参考价值和指导意义明显提升。如白塞病作为一种重要的血管炎类型终于加入分类标准中;原标准不完善时,许多单器官性血管炎、继发性血管炎往往在相应专科诊治,新标准的出现为风湿免疫科医师参与这些血管炎的诊治提供了充足的理论依据。
3)对某些疾病命名的更改体现了一个新的趋势,以往一部分血管炎以首先发现和报道的学者名字命名,随着对疾病本质的深入了解,使用能反映病因、临床特点、病变本质的名称更为合理,如韦格纳肉芽肿和Churg-Strauss 综合征,但大动脉炎(Takayasu’s arteritis)、川崎病(Kawasaki’s disease)、白塞病(Beçhet’s disease)未提出恰当的名称取代原有的命名,仍维持原有人名命名。
缺点:
1)某些类型的血管炎之间有交叉、重叠,或虽有比较清楚的定义,但临床上难以操作。如与系统性疾病相关的血管炎和与可能病因相关的血管炎,二者的定义较模糊,也未提出明确的鉴别方法;单器官性血管炎与仅累及单一器官的系统性血管炎,定义中的鉴别点仅提及是否有明确的依据诊断系统性血管炎,但临床工作中二者往往难以区分。
2)临床工作中并不少见的一些血管炎仍未列入分类标准中,如累及眼、耳、鼻、咽喉的非肉芽肿性小血管炎,在临床上时常遇到,但无法归入上述任一分类中。
10.系统性血管炎有哪些共同特点?
答:系统性血管炎有以下共同特点:
1)多种原因引起机体大、中或小血管的炎性破坏, 可最终导致多器官或组织的损害;
2)临床上因受累血管的大小、类型、部位和病理等的不同而表现各异;
3)临床最常见的系统性血管炎包括大动脉炎、结节性多动脉炎、白塞病、ANCA相关性血管炎(包括肉芽肿性多血管炎、显微镜下多血管炎及变应性肉芽肿性多血管炎)、变应性血管炎、IgA血管炎和巨细胞动脉炎等;
4)ANCA相关性血管炎患者血清中可出现不同荧光类型的抗中性粒细胞胞浆抗体;
5)对应用糖皮质激素和/或免疫*制剂抑**等治疗有效;
6)预后随血管受累部位及程度的不同而不同, 其中以结节性多动脉炎、显微镜下多血管炎及肉芽肿性多血管炎预后较差。
11.继发于肿瘤的血管炎有哪些特点?
答:1)骨髓增生异常综合征合并的血管炎以肾受累多见,易发生激素依赖性,经治疗完全缓解者较少;
2)实性肿瘤合并血管炎以外周神经受累多见;
3)淋巴样肿瘤合并的血管炎关节痛和肾受累少见。
12.哪些药物可诱发血管炎?
答:很多药物可诱发不同类型的血管炎,包括阿托伐他汀、丙硫氧嘧啶、孟鲁司特钠、肼苯哒嗪、*卡因可**、麦角胺,麻黄碱,青霉胺和米诺环素等。
13.从临床表现如何判断系统性血管炎受累血管的大小?
答:详见表1。


图3 系统性血管炎导致左侧下肢的皮肤溃疡
14.大血管炎有哪些特点?
答:1)大血管炎主要累及主动脉及其主要分支,但也有一部分大血管炎患者出现以中小动脉受累为主要的表现。
2)好发于女性;
3)所包括的大动脉炎和巨细胞动脉炎的临床表现、病理学表现有很多相似性,难以区分,最大的区别在于大动脉炎好发于年轻患者(年龄 <50 岁),巨细胞动脉炎好发于中老年患者。
15.中等血管血管炎有哪些特点?
答:1)中等血管血管炎主要包括结节性多动脉炎和川崎病两种疾病,主要累及中小动脉为主,其炎症反应往往比大血管炎更剧烈,病程更短,更易引起组织坏死。
2)结节性多动脉炎可出现四肢或躯干的网状青斑,*丸睾**痛和腓肠肌疼痛有一定特异性,可出现肾损害和周围神经病变;它与小血管炎在临床上、甚至病理上有时难以区分,但结节性多动脉炎与抗中性粒细胞胞浆抗体(ANCA)不相关也许有助于区分;
3)川崎病过去又叫黏膜皮肤淋巴结综合征,几乎只发生于婴幼儿,临床常表现为发热、皮疹、颈部非化脓性淋巴结肿大、眼结合膜充血、口腔黏膜弥漫充血、杨梅舌、掌跖红斑、手足硬性水肿等,累及冠状动脉(见图4)时预后不佳。

图4 川崎病冠状动脉造影提示明显扩张
16.小血管炎有何特点?
答:1)除IgA血管炎外,大多数小血管炎好发于中老年,男性多见;
2)几乎任何系统器官均可受累,而以肾脏和肺部受累最多,根据受累血管的不同,临床表现多种多样,相互重叠,光凭临床表现常常难以区分,病情的严重程度也各不相同,其中以ANCA 相关性血管炎临床表现较为严重。
3)临床诊断需结合症状、体征、化验和影像学及病理结果综合判断;
4)由于受累血管管径小,血管造影等影像学难以显示受累血管的病变和分布情况;
5)化验ANCA对ANCA 相关性血管炎有重要参考价值,一般的实验室指标缺乏诊断特异性,但有一定的临床意义(见表2)。
6)多需糖皮质激素联合免疫*制剂抑**如环磷酰胺等治疗。

17.我国ANCA相关性血管炎的临床特点有哪些?
答:不同研究机构由于病人来源和所采取的诊断方法不同,得出的研究结论可能不一样。北京大学第一医院肾内科的研究提示:
1)上世纪80年代,由于我国医疗工作者认识不足,临床少有诊断,90年代随着认识的深入,确诊患者逐年增加,但误诊和漏诊相当严重,从发病至ANCA检测时间均数为237.6(3~1460)天,中位数 60天,23.2% 为 30 天内确诊,11.0%确诊需要1年;
2)肾、肺最常受累:显微镜下多血管炎更易肾受累,临床可隐匿进展,易误诊为慢性肾衰,病理表现为新月体新旧不等和肾小管间质病变严重;
3)合并中小动脉病变者,肾功易恢复(类似于结节性多动脉炎),补体C3沉积者的肾损害重。
4)显微镜下多血管炎占79.1%(337/426),肉芽肿性多血管炎占20.4%(87/426),嗜酸性肉芽肿性多血管炎占0.5%(2/426);
5)ANCA的靶抗原为髓过氧化物酶和PR3的比例为6.7:1(213:32)。肉芽肿性多血管炎患者的pANCA/髓过氧化物酶阳性率为60.7%(54/ 89) 。而李胜光教授所在的风湿免疫科团队整合了解放军总医院第四临床医学中心和北京大学国际医院的临床病例进行的总结提示:在有完整随访资料的122例ANCA相关性血管炎患者中,男性66例,女性56例,确诊ANCA相关性血管炎时的平均年龄为61.6±15.5(16~88)岁。自发病到确诊时的平均病程为(18.1±29.5)月。根据2007年发布的欧洲药品会(European Medicines Agency,EMA)流程进行分类,结果为变应性肉芽肿性多血管炎13例(10.8%),肉芽肿性多血管炎 55例(45.8%),而显微镜下多血管炎 47例(39.2%)。如果采用2017年的ANCA相关性血管炎新分类标准草案进行重新分类,结果为:变应性肉芽肿性多血管炎 8例(6.7%),肉芽肿性多血管炎 32例(26.7%),显微镜下多血管炎 64例(53.3%),重叠9例(变应性肉芽肿性多血管炎+肉芽肿性多血管炎重叠1例,肉芽肿性多血管炎+显微镜下多血管炎重叠8例)。
18.我国老年ANCA相关性血管炎有哪些特点?
答:根据北大医院肾内科的研究,汇总如下:
1)老年人发病不低:占42.3%(99/234);
2)与中青年相比,老年ANCA相关性血管炎患者的肺受累较重(年龄大和肺部感染是死亡的独立危险因素),抗髓过氧化物酶抗体阳性率高达94.9%,其中,显微镜下多血管炎为79.8%,肉芽肿性多血管炎占18.2%。

19.变异性血管炎有哪些特点?
答:1)以全层血管炎为主要特征,包括白塞病和科根综合征,任何大小(大、中、小)及任何种类的血管(动脉、静脉、毛细血管)均可累及。
2)白塞病以口腔溃疡、外生殖器溃疡和眼炎三联征为典型临床表现,其血管损害主要表现为动、静脉血栓、主动脉瓣关闭不全和发生于大中血管的血管瘤等。科根综合征为罕见病,发病率极低,以间质性角膜炎和前庭听觉功能受损为主要特征,其他临床表现还包括耳鸣、眩晕、双耳感觉性听力减退,以及眼球震颤和共济失调等。
20.哪些临床表现应考虑系统性血管炎?
答:系统性血管炎无特异性临床表现,如出现无法解释的下列情况应考虑血管炎的可能:多系统损害;进行性肾小球肾炎或血肌酐及尿素氮升高;肺部多变阴影或固定阴影/空洞;多发性单神经炎或多神经炎;不明原因发热;缺血性或淤血性症状和体征;紫癜性皮疹或网状青斑;结节性坏死性皮疹;无脉或血压升高;ANCA阳性;AECA阳性。也有学者总结如果出现SKLEN样临床表现,其中S表示皮肤(skin),K表示肾脏(kidneys),L表示肺(lungs),E表示耳鼻喉(ears, nose, and throat), N表示神经(nerve),以上如有3个系统受累应考虑血管炎诊断。

图5 系统性血管炎患者右小 腿前侧有触痛性红色斑疹
21.不同年龄段易患哪种系统性血管炎?
答:见表3。

22.如何诊断结节性多动脉炎?
答:可参考1990年美国风湿病学会的分类标准来诊断,见如下表4。

23. 如何诊断肉芽肿性多血管炎?
答:可根据1990年美国风湿病学会的诊断分类标准来诊断,见如下表5。

24.如何诊断变应性肉芽肿性血管炎?
答:可根据1990年美国风湿病学会的诊断分类标准来诊断,见如下表6。

25.什么是ANCA相关性血管炎的EMA分类流程?
答:ANCA相关性血管炎迄今尚无统一的诊断标准,目前具有较好临床参考价值的是2007年欧洲药品管理局(EMA)推出的小血管炎分类流程。其分类流程是在1984年Lanham的变应性肉芽肿性多血管炎诊断标准和1990年美国风湿病学会的肉芽肿性多血管炎和显微镜下多血管炎分类标准基础上,引入了上呼吸道、下呼吸道和肾血管炎替代标记的概念,使得临床上经常容易混淆的肉芽肿性多血管炎和显微镜下多血管炎得以轻易分开(如下图6)。欧洲药品管理局关于ANCA相关性血管炎的分类流程基于以下理念:首先确定有分类标准的变应性肉芽肿性多血管炎和肉芽肿性多血管炎,然后看是否符合显微镜下多血管炎。
第一步,应用Lanham或美国风湿病学会的标准看是否符合变应性肉芽肿性多血管炎(之所以先分辨是否为变应性肉芽肿性多血管炎,是因为它的诊断特异性更高);
第二步,通过以下4条途径,只要满足其中任意一条,则可诊断肉芽肿性多血管炎:
- 是否满足美国风湿病学会的分类标准;
- 是否具有教堂山共识会议规定的肉芽肿性多血管炎病理特征;
- 是否满足教堂山共识会议规定的显微镜下多血管炎的病理特征+至少一项肉芽肿性多血管炎的替代标记;
- 是否满足ANCA 阳性+任意一项肉芽肿性多血管炎的替代标记;
第三步:通过以下两条途径诊断显微镜下多血管炎:
- 看临床和病理表现是否符合小血管炎,而且不能存在肉芽肿性多血管炎的替代标记;
- 是否满足ANCA阳性+肾血管炎的替代标记;第四步:如果以上均不符合或不满足,则诊断未分化小血管炎或者结节性多动脉炎。


图6 ANCA相关性血管炎的诊断流程图
26. 2017年ACR/EULAR关于ANCA相关性血管炎的新分类标准草案包括哪些内容?
答:2017年ACR联合欧洲抗风湿病联盟(EULAR)共同推出了新的ANCA相关性血管炎分类标准草案(见表7~表9),使得ANCA相关性血管炎的临床和研究有了新的工具。由于该套分类标准尚未正式发表,亦未获得官方验证,因此仅供临床参考。



27.如何诊断巨细胞动脉炎?
答:根据1990年美国风湿病学会的诊断分类标准来诊断,见如下表10。

28.如何诊断大动脉炎?
答:1990年美国风湿病学会的诊断分类标准见表11。2018年ACR会议及2019年国际血管炎会议均提出了新的大动脉炎分类标准:在年龄≤60岁及影像学提示有血管壁炎症的基础上,以下标准总分≥5分可诊断为大动脉炎:
1)临床症状方面:
- 女性,1分;
- 由血管炎导致的心绞痛或缺血性心脏疼痛,2分;
- 上肢/下肢跛行,2分;
2)血管体检:
- 动脉杂音 ,2分;
- 上肢脉搏减弱,2分;
- 颈部-脉搏减弱或触痛,2分;
- 上肢收缩压差≥20mmHg,1分;
3)血管造影或超声检查:
- 受累血管数量:1支血管,1分;2支血管,2分;3支或以上,3分;
- 血管炎症累及双侧动脉,1分;
- 腹主动脉伴肾动脉或肠系膜动脉受累,3分。应注意与先天性主动脉狭窄、感染性主动脉炎、动脉硬化、结节性多动脉炎、白塞病、IgG4相关性疾病、复发性多软骨炎等疾病鉴别。

29.诊断ANCA相关性血管炎应注意哪些?
答:1)一部分肉芽肿性多血管炎/嗜酸性肉芽肿性多血管炎患者病变仅局限于呼吸系统,无其他器官、系统受累依据,但临床及病理学表现与肉芽肿性多血管炎/嗜酸性肉芽肿性多血管炎累及呼吸道的患者完全一致,常将这部分患者归为肉芽肿性多血管炎/嗜酸性肉芽肿性多血管炎,而非单器官性血管炎(尤其当 ANCA 阳性时);
2)嗜酸性肉芽肿性多血管炎的血管外表现往往为非肉芽肿性;
3)ANCA 阳性的嗜酸性肉芽肿性多血管炎患者的肾损害发生率高;
4)感染、肿瘤等疾病也可表现为发热和ANCA阳性,需注意排除。尤其相当一部分亚急性感染性心内膜炎患者可伴有ANCA阳性。
30.如何鉴别显微镜下多血管炎、变应性肉芽肿性血管炎及肉芽肿性多血管炎?
答:见表12。

31.系统性血管炎如何判断病情活动?
答:主要采用伯明翰系统性血管炎活动评分(Birmingham Vasculitis Activity Score)标准,见表13。其应用最广,从患者过去4周汇总9个方面的情况,各系统评分有最高限,9单项总评分最高63分,如≥15分为病情活动。

32.检测抗中性粒细胞胞浆抗体(ANCA)有哪些临床意义?
答:1)抗中性粒细胞胞浆抗体在显微镜下主要分为两种类型——胞浆型(c-ANCA)和核周型(p-ANCA),见图7,分别对应于靶抗原蛋白酶3(PR3)和髓过氧化物酶(MPO),即PR3-ANCA和MPO-ANCA,通过ELISA方法可以检测出来,比荧光免疫法的检测结果更具特异性。
2)国外报道,c-ANCA和PR3-ANCA与肉芽肿性多血管炎具有更高的敏感性和特异性;而p-ANCA和MPO-ANCA与显微镜下多血管炎具有更密切的相关性,两者均可作为相应疾病诊断和治疗的监控指标。
3)存在下列疾病时可出现假阳性:①感染性疾病:艾滋病,心内膜炎,胰纤维性囊肿(继发感染),病毒性肠炎等,②肿瘤:心房粘液瘤,结肠癌,支气管癌,非何杰金淋巴瘤等, ③其他:炎症性肠病、自身免疫性肝病、嗜酸细胞增高性纤维肌痛综合征,Sweet综合征等。

33.判断系统性血管炎病情活动的实验室指标有哪些?
答:1)MPO-ANCA和PR3-ANCA,滴度增高,提示疾病活动性增高,滴度减低提示疾病活动度减低。
2)血沉和C-反应蛋白:两者增高均提示疾病活动性增强,其中C-反应蛋白比血沉具有更高的判断价值,但在大血管炎中血沉升高似乎更有价值;
3)血清金属蛋白酶3,血管内皮生长因子;
4)血清白介素-25和白介素-32 :前者主要由嗜酸细胞产生,与嗜酸性肉芽肿性多血管炎的病情活动相关,后者可能与肉芽肿性多血管炎的病情活动相关,并与疗效相关;
5)血清中性粒细胞明胶酶相关脂质运载蛋白:也称脂质运载蛋白-20。与伯明翰系统性血管炎活动评分、血沉、C-反应蛋白和ANCA水平相关(与伯明翰系统性血管炎活动评分的相关性更强);
6)血清骨桥蛋白;
7)PET-CT:有助于大血管炎病情活动判断,见图8。
8)PTX-3(正五聚蛋白-3)、IL-6可用于大动脉炎的疾病活动性评估。

图8 大血管炎患者PET-CT显示降 主动脉和髂动脉有18F-FDG摄取
34.ANCA增高能判断为ANCA相关血管炎病情活动吗?
答:ANCA滴度升高可能提示病情活动,但需要结合具体的临床表现。有研究提示,一方面,ANCA滴度升高者中,48%在随访中出现了病情活动,另一方面,在所有复发者,有51%的患者出现ANCA滴度升高,ANCA滴度不升高而出现病情活动者很少。当然,判断ANCA相关性血管炎是否有病情活动是一个较复杂的过程,需要借助的工具很多,较常用的包括:伯明翰血管炎活动性评分(BVAS)-1994、BVAS-2003及BVAS/WG,系统性血管炎损伤指数评估量表(VDI)和疾病累及范围指数(DEI)及系统性血管炎疾病预后评估量表5因子评分(FFS)-1996和FFS-2009等,因此,患有该类疾病的患者应该到医院找专科医师进行这些专业的评估。
35.如何判断大动脉炎的病情活动?
答:1994年,Kerr等提出近一个月符合以下4项标准中2项以上者为病情活动:
1)全身症状如发热、多关节痛和多肌痛,排除其他原因;
2)近期出现血管缺血或炎症:肢体跛行,四肢脉搏或血压不能触及或减弱,青紫,或血管性疼痛;
3)血管造影异常;
4)血沉升高。
此外,血管超声造影或全身血管MRA见动脉管壁增厚和强化、影像学提示血管受累加重也提示大动脉炎疾病活动。
36.系统性血管炎的治疗原则是什么?
答:1)快速诊断;
2)快速个体化治疗(根据有无器官受累及病情活动选择不同治疗方案);
3)联合用药诱导缓解;
4)维持缓解,尽可能减少激素剂量;
5)预防药物毒性;
6)脏器功能支持和替代;
7)内科治疗效果不佳可考虑血管成形术和旁路术。
37.治疗ANCA相关性血管炎用环磷酰胺冲击还是口服更好?
答:1)与口服(3~6个月)相比,环磷酰胺冲击(6~9个月)诱导缓解率稍高,可能更利于诱导缓解,缓解速度及对靶器官(肾)保护上无明显差别;
2)与口服相比,环磷酰胺冲击的副作用较低,白细胞降低发生率较低,而感染和绝经等无明显差别;
3)与口服相比,环磷酰胺冲击的复发风险较高。
38.ANCA相关性血管炎如何治疗?
答:1)糖皮质激素:强的松/强的松龙 1mg/(kg.d),目标为3个月内渐减到15mg/d以下。
2)环磷酰胺:首选的免疫*制剂抑**,后来研究证实,血肌酐<4 mg/dl(354μmol/l)的ANCA相关性血管炎患者用利妥昔单抗的有效性与环磷酰胺诱导/硫唑嘌呤维持一样。2009年欧洲血管炎研究小组根据病变范围、程度和药物疗效,把ANCA相关性血管炎分为五型,其治疗推荐如表14。
- 局限型 (localized) :即上和/或下呼吸道受累,无任何其他系统受累或全身症状。可用糖皮质激素联合甲氨蝶呤(口服或其他途径),甲氨蝶呤起始15mg/周,如可耐受,1~2个月内渐增至20~25mg/周,应监测甲氨蝶呤浓度;
- 早期全身型:无危及器官或生命损害的任何情况,治疗同局限型。
- 弥漫型:有肾或其他危及生命的器官受损,血肌酐<500 μmol/L (5.6 mg/dL),治疗见表14。
- 严重型:有肾或其他重要脏器功能衰竭,血肌酐>500 μmol/L (5.6 mg/dL),治疗见表6。
- 难治型:对激素和环磷酰胺无效的进展型,治疗见表14。2019年在《Kidney International》上发表了ANCA相关性血管炎的治疗流程图,见图9。


图9 ANCA相关性血管炎的治疗流程

39.ANCA相关性血管炎的维持缓解用哪些药物?有何优缺点?
答:ANCA相关性血管炎的维持缓解期常用药见表15。
1)硫唑嘌呤与口服环磷酰胺一样有效,且更安全,致畸性低和诱发肿瘤较少,但功能性巯基嘌呤甲基转移酶缺陷者可发生严重骨髓抑制。
2)与霉酚酸酯相比,硫唑嘌呤更有效,副作用相似。
3)与甲氨蝶呤相比,硫唑嘌呤的疗效、副作用和复发率无明显差别。
4)与甲氨蝶呤相比,来氟米特更有效,维持缓解复发率低(肉芽肿性多血管炎) ,但副作用更大;
5)利妥昔单抗。

40.血浆置换可用于ANCA相关性血管炎的治疗吗?
答:1)对于快速进展肾病等危及生命的情况可配合血浆置换(1B级证据,*级A**推荐)。
2)回顾性研究显示,血浆置换对严重肾衰伴弥漫性肺泡出血及抗肾小球基底膜抗体有益;
3)严重肾炎者 (肌酐>5.7mg/dl),血浆置换有助于急性肾衰者脱离透析;
4)不支持长期行血浆置换。
41.与环磷酰胺相比,利妥昔单抗治疗ANCA相关性血管炎有何优缺点?
答:利妥昔单抗是一种针对CD20的单克隆抗体的靶向治疗。与环磷酰胺相比,利妥昔单抗治疗ANCA相关性血管炎的特点是:
1)缓解病情速度更快,复发病例的缓解率更高;
2)累积缓解率、复发率、死亡累积发生率、终末肾病发生率和严重副作用发生率相似。因此,利妥昔单抗诱导治疗ANCA相关性血管炎,虽然还不能替代环磷酰胺,但不劣于环磷酰胺,可作为候选方案, 尤其是复发病例。
42.利妥昔单抗可用于ANCA相关性血管炎的诱导缓解吗?如何用?
答:可以用,利妥昔单抗治疗ANCA相关性血管炎的流程见图10。2016年欧洲抗风湿病联盟联合欧洲肾脏学会-欧洲透析和移植学会对治疗ANCA相关性血管炎的建议如下:
1)适应证:①新诊断ANCA相关性血管炎,诱导缓解疗效与环磷酰胺相同,可用于有环磷酰胺禁忌症患者;②难治或复发性ANCA相关性血管炎,疗效肯定;③不同类型ANCA相关性血管炎:头颈部受累肉芽肿性多血管炎和儿童ANCA相关性血管炎均可考虑用。
2)用法:如下两种方法均有效,但无对比实验。一是每周用375mg/m2,连续4周;第二种是每2周用1000mg,用2次;近些年推出了小剂量方案,用法是每次375mg/m2,相隔2周共使用2次。不建议常规加环磷酰胺,只有在有严重威胁器官或生命状况如急进肾小球肾炎时为快速控制疾病,可考虑加环磷酰胺,用利妥昔单抗治疗后是否继续用其他免疫*制剂抑**尚无定论,首次利妥昔单抗可予静脉或口服大剂量激素快速控制病情,激素减量方法无推荐。
3)疗效:对新诊断ANCA相关性血管炎的长期预后是否优于传统疗法尚缺证据,但对难治性ANCA相关性血管炎总体疗效优于其他疗法。利妥昔单抗诱导缓解后应密切随访,如复发可推荐再次用,提前再次用可降低复发率。
4)安全性:尚无证据证明增加严重感染风险, 药物相关的其他副作用发生率与其治疗其他疾病相似,建议首次用利妥昔单抗前至少1个月注射疫苗。

图10 利妥昔单抗治疗ANCA相关性血管炎的流程图
43.利妥昔单抗可用于ANCA相关性血管炎的维持缓解治疗吗?如何用?
答:2020年2月,英国专家小组制定了利妥昔单抗用于ANCA相关性血管炎维持缓解的治疗指南。
1)肉芽肿性多血管炎/显微镜下多血管炎新发和复发患者用利妥昔单抗诱导治疗后,建议用利妥昔单抗维持缓解,在应用环磷酰胺诱导治疗后也可考虑用利妥昔单抗维持治疗。
2)嗜酸性肉芽肿性多血管炎患者:利妥昔单抗用于维持缓解的证据有限,整体治疗反应可能不及肉芽肿性多血管炎和显微镜下多血管炎,停用糖皮质激素对这类患者可能更具挑战性,使用方法与肉芽肿性多血管炎和显微镜下多血管炎相同。
3)方法:以固定的间隔应用,每半年用500 mg或1000 mg,为期2年,停药后存在持续复发风险,应监测,如果复发,或有ANCA持续升高或复发后可能危及器官和生命,应延长治疗时间,可拉长时间间隔,半年到1年用500~1000mg,最多治疗5年。根据疾病活动度和器官受累的严重程度来确定,可参考ANCA和B细胞恢复情况指导维持治疗。
4)如果正在用硫唑嘌呤、甲氨蝶呤或吗替麦考酚酯维持缓解治疗者,准备换用利妥昔单抗时,应停用现有这些药。
5)对于所有接受利妥昔单抗维持治疗的患者建议预防卡氏肺囊子菌感染,接种流感和肺炎球菌疫苗,最好在接受利妥昔单抗治疗前至少1个月接种,避免接种活疫苗,治疗时机不影响疫苗接种。
6)利妥昔单抗维持治疗时,所有患者都应监测免疫球蛋白,如果出现复发或非典型感染,或IgG <3 g/L(儿童年龄范围内,IgG低于正常年龄下限),建议进行进一步检查,低丙种球蛋白血症患者可考虑同时用利妥昔单抗和丙种球蛋白,如果发生迟发性中性粒细胞减少,不再使用利妥昔单抗。
44.难治性ANCA相关性血管炎如何治疗?
答:1)丙种球蛋白冲击:400mg~2g/kg.d,冲击5天;
2)吗替麦考酚酯1~2g/d 口服;
3)15-脱氧精胍素 0.5mg/kg.d 皮下注射,直到白细胞最低,然后停用直到恢复正常(6个循环);
4)抗胸腺球蛋白 2.5mg/kg.d ,静脉输液,用10天(根据淋巴细胞数调节);
5)静脉用利妥昔单抗;
6)英夫利昔单抗3~5mg/kg,静脉输液,每月 1~2次;
7)造血干细胞移植或间充质干细胞移植:自体造血干细胞移植有效,但费用高;异体造血干细胞移植有效,但要抗排异,不但费用高,死亡率也较高;自体和异体间充质干细胞移植有效,异体间充质干细胞移植后不需抗排异;
8)阿伦单抗(Alemtuzumab,人源化抗CD52单抗):可清除淋巴细胞和单核细胞。
45.系统性血管炎患者,是否可配合中医中药治疗呢?
答:可以。
46.ANCA相关性血管炎最终是否可停药?
答:不能停药,需要降阶梯维持治疗。有研究显示,诱导缓解后维持治疗的患者停用甲氨喋呤或硫唑嘌呤,复发率高达73%,大多数病情复发都在霉酚酸酯和硫唑嘌呤减量后。
47.ANCA相关性血管炎容易复发吗?
答:较易复发。复发的高危因素是:
1)抗PR3-ANCA抗体阳性的肉芽肿性多血管炎,特别是上呼吸道和下呼吸道、眼睛和耳受累者。
2)诱导治疗强度不够;
3)过早停用糖皮质激素或免疫*制剂抑**;
4)诱导缓解后ANCA持续阳性或滴度增高,或慢性鼻部金黄色葡萄球菌感染。
48.ANCA相关性血管炎复发如何治疗?
答:需要根据复发的严重程度决定。首次诱导成功的方案仍可以作为一线治疗再使用。如果复发不严重,可短暂增加糖皮质激素的剂量,如每日0.5mg/kg可能控制病情进展。免疫抑制药可换用利妥昔单抗,有研究认为,复发病例用利妥昔单抗比环磷酰胺更好。
49.ANCA相关性血管炎患者有哪些日常注意事项?
答:1)规律用药,定期复诊,治疗初期每个月复诊1次,治疗后期或维持缓解期每3~6个月复诊一次,注意观察有无发热、关节肌肉疼痛、皮疹、血尿等,如出现,及时就诊。
2)需长期用药治疗,不能擅自停药和改变药物剂量,病情稳定2年以上的患者,可在医生指导下,逐步减少药物,但停药需谨慎再谨慎。
3)有肾功能受损的患者建议优质蛋白饮食,控制蛋白质总量,每日每公斤蛋白质不超过0.8克,限制水和盐的摄入量;
4)适当运动,强度和时间根据总体健康状态而定,需要循序渐进,避免过度。
50.系统性血管炎患者是否可抽烟喝酒?
答:不建议吸烟喝酒。
51.维生素D缺乏的系统性血管炎患者能晒太阳吗?
答:这个需要看患者是否对紫外线过敏,部分患者可能存在日晒后过敏,可能诱发自身免疫异常,而不能晒。当然,多数患者不存在日光过敏,可适当日晒,但不能暴晒。

52.育龄期女性最常见的系统性血管炎是哪一种?
答:系统性血管炎包括很多种,育龄期最多见的系统性血管炎是大动脉炎和白塞病。
53.系统性血管炎对女性生育功能有哪些影响?
答:1)如果营养卵巢和子宫的血管没有受累,则系统性血管炎一般不会影响女性生育能力;
2)病情严重导致重要脏器受累,则女性无法完成生育任务;
3)如果病情严重而使用大剂量糖皮质激素或环磷酰胺等治疗,可能导致月经期紊乱、无排卵周期甚至闭经,则影响生育。
54.系统性血管炎患者妊娠对原发病有无影响?
答:1)根据系统性血管炎的类型不同,可能影响不一样。
2)大动脉炎患者怀孕后一般不会病情恶化,有个别报道孕期大动脉炎有改善,产后大动脉炎的炎症反应未加重;
3)白塞病:妊娠期2/3的患者病情恶化,1/3缓解,原发病和妊娠本身易导致血栓形成,皮肤粘膜型在妊娠初期易发生病情恶化。病情改善者在产后、月经期或月经后有病情反弹现象;
4)结节性多动脉炎:疾病本身发生中、小动脉狭窄,在此基础上并发妊娠期高血压会加重不良妊娠;
5)肉芽肿性多血管炎:缓解期患者在孕期的复发率为25%,孕期病情活动常见于孕早、中期或产后,且取决于器官受累程度。疾病活动期合并妊娠或在妊娠期间发病者是孕妇与胎儿死亡的高危因素。妊娠期间发病者或疾病活动者易发生早产。
55.是小血管炎还是大血管炎更加影响怀孕?
答:没有相应的报道,不管大血管炎还是小血管炎,是否影响怀孕关键看如下情况:
1)是否有重要脏器受累,如果发生了高血压、肾功能不全、充血性心力衰竭和脑血管意外等,则肯定影响怀孕。
2)是否影响供应子宫和卵巢的血管,如果累及,则肯定影响怀孕;
3)是否长期大剂量使用了环磷酰胺和雷公藤多甙:这两种药物会导致卵巢功能减退,甚至绝经。
4)是否使用了易致畸的慢作用抗风湿药物:沙利度胺必须停用半年以上,甲氨蝶呤、霉酚酸酯等药物需停用3~6月,来氟米特需停用2年或消胆胺洗脱。
56.大动脉炎患者反复出现不良妊娠,一定是病情活动导致的吗?
答:不一定。可能的原因是:
1)大动脉炎早期疾病活动;
2)大动脉炎的并发症:高血压、肾功能不全、充血性心力衰竭和脑血管意外,妊娠期由于血容量明显增加,各脏器(如心、肾)负担加重,可导致上述并发症加重;子痫前期的发生率也很高,尤其是孕前就有脏器受累的患者。此外,由于合并症的发生、子宫动脉血流减少,均可导致胎儿宫内状况不良,易发生自然流产、早产、胎儿发育迟缓,甚至胎死宫内。因此大动脉炎合并妊娠出现妊娠并发症和不良妊娠结局的风险明显增加。有关并发症及妊娠结局的报道不一。Sharma等报道了12例大动脉炎患者的24次妊娠,其中11例腹主动脉受累、9例肾动脉受累。妊娠结局 5例为小于胎龄儿、4例早产、2例流产、5例胎死宫内;妊娠并发症包括4例子痫前期、2例充血性心衰及肾功能不全。认为基础血压水平决定了疾病对妊娠的影响,血压>180/106 mmHg、腹主动脉受累、就诊时间晚是胎死宫内患者的共同特点,也是导致胎儿发育迟缓的重要因素。Gasch等总结了报道的137次妊娠,流产率15%、早产率8%,15%的新生儿出生体重低,39%的母亲发生子痫前期。
3)合并产科抗磷脂综合征。
4)其他因素:子宫解剖因素,内分泌因素和遗传因素等。
57.系统性血管炎患者可以怀孕吗?
答:系统性血管炎患者是否可以怀孕取决于:
1)病情是否平稳:如果在病情不稳定,怀孕则可能加重病情,导致不良妊娠;
2)是否存在重要脏器的受累:怀孕可使已受损重要脏器的负担加重,导致不良妊娠;
3)是否已停用对胎儿毒性较大的药物足够时间:很多毒性较大的药物如环磷酰胺,需要停足够时间并调整为对妊娠相对安全的药物,才能怀孕。所以,孕前必须请风湿免疫科医生评估病情后,确定怀孕时机。
58.系统性血管炎患者孕前应该进行哪些评估?
答:1)综合评估:根据既往孕产史、系统性血管炎病史、当前疾病活动度、最后发作时间、大动脉受累范围、脏器损害程度及功能状态和最近血清学检查结果等情况,评估患者是否可以备孕;
2)如果病情稳定至少6个月以上,无重要脏器受累和使用毒性较大的药物(停用足够时间),可考虑备孕。
59.系统性血管炎患者什么时候可妊娠?
答:1)病情稳定至少半年到一年以上,有些需要维持缓解至少2年,而PR3-ANCA持续阳性的肉芽肿性血管炎需治疗5年;如果以前有尿蛋白,建议24小时尿蛋白定量<0.5g ;
2)无重要脏器损害;
3)糖皮质激素剂量强的松<15mg/日;
4)停用免疫抑制药物(环磷酰胺、甲氨蝶呤、 雷公藤等)半年以上;而来氟米特需要停2年或者消胆胺洗脱后血液中未见残留。

60.系统性血管炎患者在哪些情况下不能怀孕?
答:1)病情在活动期;
2)有重要脏器严重受累的:如重度限制性肺部疾病;慢性肾功能衰竭;严重肺动脉高压;中重度心功能衰竭;未控制的高血压等;
3)既往有过子痫前期,尤其是曾经使用阿司匹林及肝素治疗后仍出现严重的早发性子痫前期。
61.大动脉炎分很多类型,哪个类型影响怀孕最大?
答:大动脉炎临床分型根据Lupi.Herrera分类,按血管病变部位分型:I型:头臂动脉型,主要累及主动脉弓及其分支;II型:胸腹主动脉型,主要累及降主动脉以及腹主动脉;III型:广泛型,具有以上两种临床特征;IV 型:肺动脉型。其中广泛型影响最大,头臂动脉型影响最小。协和医院有一个7例患者的统计数据,其中头臂动脉型患者3例,孕前血压正常,经密切监测随访,无妊娠并发症及不良妊娠结局发生,均维持妊娠到足月,2例自然分娩,1例因产科因素行剖宫产。广泛型患者3例,2例孕前患有高血压者继发子痫前期,1例发生左心衰,1例孕 25周就诊时发现肾功能不全。
62.用多长时间的环磷酰胺会导致卵巢功能减退和绝经呢?
答:1)环磷酰胺导致生殖毒性是公认的,这是由于环磷酰胺的活性代谢产物是通过与DNA细胞内酶及蛋白质交联而产生对卵巢的毒性,使初级卵泡和次级卵泡的数量明显减少,可造成卵巢功能衰竭,引起闭经和不孕。一项研究《环磷酰胺对大鼠卵巢功能的影响》结果提示,环磷酰胺作用下卵巢形态学改变显著的是原始卵泡数目减少,提示这可能是其减少卵巢储备量,致卵巢功能受损的主要机制之一。
2)环磷酰胺是否诱发生殖毒性与用药时间、累积剂量及初始年龄有关。6项研究的荟萃分析提示,环磷酰胺的累积剂量在12~25g之间,年龄40岁以上,且治疗时间超过6个月以上,约有1/3患者最终会发展为卵巢功能衰竭。
63.为了保存生育力,使用环磷酰胺的ANCA相关性血管炎患者怎么办?
答:1)为了避免环磷酰胺治疗的年轻女性出现原发性卵巢功能不全,条件性推荐每个月使用促性腺激素释放激素激动剂联合治疗,可逆性抑制下丘脑-垂体-卵巢轴,引起假性绝经,下调垂体促卵泡生成素和促黄体生成素分泌,降低雌激素和孕激素,阻止原始卵泡成熟,使卵巢中卵泡处于对环磷酰胺低敏感状态,减少卵巢血运,减少卵巢局部环磷酰胺浓度,用法是亮丙瑞林3.75mg(体重<50kg减半)皮下或肌肉注射,每4周1次,共3~6个月,用环磷酰胺前2周用(不与环磷酰胺同时用,否则致卵巢损伤),第1次注射后3~8周无月经,性激素降低, 注射停止后6~12周月经恢复,副作用主要是绝经期综合征(25%有潮热)、血凝异常和骨质疏松。
2)长期用环磷酰胺的患者也可低温保存卵泡、卵母细胞或胚胎。
64.因环磷酰胺治疗导致绝经的ANCA相关性血管炎患者,想怀孕生孩子,怎么办呢?
答:1)评估卵巢功能:查基础性激素、妇科超声及抗苗勒氏激素等,综合评价,小部分患者虽然已绝经,但如果停用环磷酰胺足够长时间,仍有恢复月经和卵巢功能的可能性。如我们曾遇到一例弥漫大B淋巴瘤患者,使用环磷酰胺后出现闭经,停用环磷酰胺并长期服用激素维持月经5年,之后因出现结缔组织病,长期口服硫酸羟氯喹维持,用药期间自行怀孕。
2)可试用一些改善卵巢功能的药如辅酶Q10、DHEA、维生素E、蒲公英T1口服液等,数月后评估卵巢功能的改善情况;
3)可试用人工周期和促排卵措施;
4)借卵进行辅助生殖。
65.系统性血管炎患者肾功能不全,查BUN 12mmol/L, 肌酐134umol/L,能否怀孕?
答:不建议怀孕。怀孕后,随着月份的增加,胎儿的增长,会增加心、肺、肾脏的负担,易加重病情,往往出现难以控制的血压增高,心衰及肾衰等,同时也可能导致不良妊娠出现,建议肾功能恢复后再怀孕。
66.大动脉炎患者,四肢血压不同,左上肢是150/90mmHg, 右上肢是120/70mmHg, 能否怀孕呢?
答:双侧上肢血压差别大可能因为上肢动脉有受累狭窄,能否怀孕取决于重要脏器的血管有无受累,脏器功能是否正常。如果均正常,且无病情活动,仅双侧上肢血压不相同,经过风湿免疫科和妇产科的评估后,考虑可怀孕。
67.结节性多动脉炎患者出现假性动脉瘤,能否怀孕生育?
答:结节性多动脉炎是主要侵犯中小肌性动脉,呈节段性分布,多发生于动脉分叉处,并向远端扩散。因血管壁内弹力层破坏,在狭窄处近端因血管内压力增高,血管扩张形成动脉瘤。少数病例可因动脉瘤破裂而致内脏出血,怀孕后由于腹部压力的增高,可能加重出血的机率,出现危险,故而不建议怀孕生育。

68.系统性血管炎患者一个月前刚做了血管造影,影响怀孕吗?
答:为规范临床诊治以及指导妊娠期和哺乳期影像学检查的选择及解读,美国妇产科医师学会联合其他相关部门制定了专门的指南。其中指出X线和CT的原理基本相同,均存在电离辐射,对胎儿存在致死及致畸性,但是其对胎儿影响的大小主要与检查时的妊娠时期及辐射剂量相关。如果非常高的暴露发生在胚胎早期,其对胚胎是致命的,但是实际上,在诊断性成像中并不会使用如此高的剂量。尽管碘造影剂可通过胎盘,但是动物研究表明其并无致畸或致突变效应。为确保安全,建议造影剂仅在可给胎儿或孕妇带来绝对影响治疗的诊断信息时方可使用。怀孕前两周内如果接受了高于10rads的X线照射,可能会杀死胚胎,但是这是一个全或无的关系,也就是说如果胎儿存活了,就没有问题。
69.患者母亲有系统性血管炎,女儿查ANA1:320阳性,但无症状,怀孕需用药吗?
答:1)系统性血管炎有一定的遗传倾向,但不是遗传病,ANA已阳性,提示存在自身免疫异常的问题,可进一步多查一些免疫学项目;
2)对于无任何不良妊娠史的患者,孕期可在看妇产科同时,每1~3个月到风湿免疫科进行各项指标的监测,防止出现不良妊娠。
3)如果是已出现多次不良妊娠史的患者,则孕期可能需要使用一些药物,防止再次出现不良妊娠。
70.系统性血管炎患者的ANCA为长期高滴度阳性,需要降低到多少才能怀孕?
答:虽然多数情况下,ANCA高滴度阳性可能提示血管炎病情的活动,如果脏器损害已恢复正常半年以上,提示病情活动的其他指标如C-反应蛋白和血沉等也均正常或接近正常,或者经过专业的BVAS评估证明疾病处于非活动期,那么,仅有高滴度ANCA阳性,即使不降低,在不停用治疗药物基础上,应可怀孕,但孕期需要密切观察。
71.系统性血管炎患者结婚4年没怀孕,可以做试管婴儿吗?
答:1)首先检查不孕的原因,不孕不一定是系统性血管炎导致的;
2)如果查到不孕原因并进行治疗,仍持续半年到1年以上不孕,可做试管婴儿,但应处在疾病稳定期、并在风湿免疫科医生密切观察病情基础上进行。
72.如果系统性血管炎患者做试管婴儿,用促排药和性激素类药,会导致病情加重吗?
答:即使在病情稳定期,系统性血管炎患者做试管婴儿导致病情恶化的可能性不能排除。因辅助生殖期间所使用的卵泡刺激素和黄体生成素可促雌激素分泌,或直接补充的的雌激素一方面可调节CD4+T细胞的分化方向,抑制Th1细胞增殖,促进Th2细胞增殖,打破Th1/Th2平衡,有利于怀孕,但另外一方面,可诱导多克隆B细胞活化,抑制自身反应性B细胞凋亡,使自身抗体增高,导致病情加重。
73.大动脉炎患者因动脉狭窄放置支架,长期用华法林和阿司匹林抗凝,孕后怎么办?
答:阿司匹林和氯吡格雷在孕期是安全的,但华法林在怀孕期间必须停用,防止胎儿畸形,可考虑使用低分子肝素替代。孕期注意大动脉炎是否病情活动,以及支架部位的再生血栓。
74.系统性血管炎患者在妊娠期间如何治疗?
答:1)建议不停用维持缓解的毒性小的药物如强的松等,孕期持续服用;
2)定期监测药物毒性和病情活动性,随时调整方案;
3)如果合并抗磷脂综合征等易栓症,可考虑加用阿司匹林和/或低分子肝素等。
75.系统性血管炎患者孕期需要监测哪些项目?
答:1)监测血压、病情活动度、并发症和药物毒性;
2)风湿科需要定期查血、尿常规、肝肾功能、甲状腺功能、糖和脂代谢指标、血沉、C反应蛋白、凝血功能、免疫球蛋白、自身抗体谱和补体、血栓弹力图及易栓筛查等;
3)妇产科需要定期做胎儿检测:包括超声多普勒子宫-胎盘血流改变、胎盘回声变化、羊水量变化及临床检查与超声检查的胎儿生长发育评估等。
76.系统性血管炎患者在孕期病情活动,该怎样处理?
答:1)如果在孕早期(前三个月)病情中重度活动,建议终止妊娠,如果病情轻度活动可考虑激素短期加量,病情稳定后减量至强的松15mg/日以下维持;
2)孕中后期出现病情加重,可以考虑甲强龙冲击和或增加免疫*制剂抑**,如硫唑嘌呤,他克莫司或环孢素等,如果病情控制不佳,则可终止妊娠。
77.系统性血管炎患者妊娠期可使用哪些药物?
答:1)磷酸氯喹和硫酸羟氯喹:FDA分级中属于C类,对胎儿是安全的,备孕期、妊娠期全程、哺乳期均可使用。由于孕期服用硫酸羟氯喹观察的例数多于磷酸氯喹,且在母体组织中的浓度在前者低于后者,故孕期服用硫酸羟氯喹比磷酸氯喹好。美国儿科学会认为可用于哺乳期。
2)硫唑嘌呤:FDA分级 D级,可在妊娠期及哺乳期使用,但不作为一线用药,仅用于病情较重者,且剂量应低于2mg/kg.d,如果剂量高,则有发生胎儿红细胞生成受抑的风险。
3)环孢素A: FDA药物分类中属于C类,孕期可服用最低有效剂量,2.5~5.0mg/kg.d,用于难治性患者,哺乳期应禁用。
4)糖皮质激素:可口服中短效的强的松和甲泼尼龙,但在怀孕的前3个月内应以最小剂量(避免增加口裂风险)治疗。长期用激素者在围产期需适当增加剂量。
5)非甾类抗炎药:怀孕的前32周内优先使用半衰期短的药物如洛索洛芬。怀孕7个月后应停用,最好间断服用最低有效剂量的非甾类抗炎药,以降低胎儿不良反应的风险。
6)丙种球蛋白:在妊娠期母亲疾病严重且难治时,可根据情况静脉给予丙种球蛋白。
以下是2020年ACR推荐的风湿与骨骼肌肉疾病生殖健康管理指南罗列了主要的抗风湿药物在孕前、孕期和哺乳期的使用指南,供参考,见表16。
表16. 2020年ACR推荐抗风湿药物在
孕前、孕期和哺乳期的使用指南

78.系统性血管炎患者孕期感冒怎么办?
答:1)基本处理:多饮开水或姜糖水,饮食清淡,多食蔬菜水果,保持大便通畅,注意休息,使用不含碘制剂的止咳药,头痛发热者,可口服扑热息痛等,孕晚期不用非甾类抗炎药。
2)不同孕期:孕早期感冒对胎儿的影响相对较大,流感病毒或感冒药都有可能对胎儿造成致畸如胎儿先天性心脏病、兔唇及神经系统畸形等,严重者可能会被建议终止妊娠。孕中期和孕晚期感冒对胎儿的影响相对较小,用药相对安全。若感冒严重,长时间高烧会妨碍子宫内胎儿的发育,剧烈咳嗽也可能引起早期破水,甚至是早产。
3)严重程度:轻微感冒无需服感冒药,一周可自行痊愈,对胎儿不会有什么影响。症状较严重者,特别是持续高烧不退和剧咳,有可能对胎儿造成一定的影响,尽快就诊。
4)是何种原因造成的感冒:由流感病毒引起的感冒可用奥司他韦(达菲,75mg,口服,每日2次)、扎那米韦、阿昔洛韦、万乃洛韦、帕拉米韦、阿比朵尔、蒲地兰口服液、板蓝根和小柴胡等,禁用利巴韦林。由细菌感染引起的感冒可用青霉素类、头孢类、大环内酯类(阿奇霉素,红霉素)抗生素。

79.系统性血管炎患者孕期出现肝损害怎么办?
答:1)完善化验,明确肝损害原因,对症处理,使用易善复、肝泰乐、双环醇或复方甘草酸苷注射液等保肝治疗;
2)注意多休息,适量多喝有保肝作用的蜂蜜水等;
3)减少或停用对肝有损害作用的药物。
80.系统性血管炎患者孕期腹泻怎么办?
答:1)多休息,喝有咸味的白粥,多喝盐水,多吃维生素c和叶酸丰富的食物,避免吃辛辣油腻不消化的食物;
2)严重腹泻及时就诊,因可能导致宫缩引起流产,进行必要的检查如大便常规和血常规等,判断是病毒、细菌感染还是肠道功能紊乱等,补水分和电解质(尤其是钾离子),控制感染,使用黄连素和或思密达等止泻,适当服用益生菌,调整肠道菌群。
81.系统性血管炎孕妇容易感染新冠肺炎病毒吗?
答:不能笼统地说,是易感还是不易感,需具体分析。
1)人类对新冠病毒普遍易感:该病毒上的S蛋白与人体粘膜上普通存在的ACE2受体结合,尤其深部远端肺泡,导致肺泡损伤,肺泡腔内大量粘液渗出和肺间质纤维化,呼吸衰竭;
2)平时机体免疫力:平时从不感冒发热,很少出现感染性疾病,也许不易感染新冠肺炎病毒;
3)药物因素:如果使用了硫酸羟氯喹,可能对预防新冠肺炎病毒起到一定的防治作用;而环孢素或他克莫司等可能降低免疫,而增加感染风险;
4)检查项目如外周血中NK细胞的数量、比例和毒性增高,CD4+T细胞增高者,可能不容易感染新冠肺炎病毒。

82.用硫酸羟氯喹治疗的系统性血管炎孕妇能预防新冠肺炎发生吗?
答:从理论上来说,硫酸羟氯喹(简称羟氯喹)和磷酸氯喹(简称氯喹)可能有这种预防作用,但需要进一步的研究证实。在体外细胞实验中,羟氯喹或氯喹可抑制新型冠状病毒生长。来自中国和其他国家的临床试验,也发现对治疗新冠肺炎有效,其作用机制可能是:
1)能够抑制病毒的基因表达,从而抑制病毒复制;
2)通过抑制自噬反应,干扰病毒的感染和复制。
3)提高细胞内的PH值,抑制病毒繁殖。
4)可抑制冠状病毒表面的S蛋白,并改变人体ACE2受体结构;
5)降低包括磷酸醋酶A在内的多种酶的活性、降低前列腺素的合成和减少白三烯从肺脏的释放,稳定溶酶体膜和抑制溶酶体酶释放。
83.系统性血管炎患者能否通过做三代试管筛查致病基因,不让孩子得病?
答:系统性血管炎的发病有一定的遗传因素,但不是遗传病,也不是单基因病,而且可能与多个基因相关,所以无法筛选出无多个致病基因的胚胎。
84.系统性血管炎患者想做试管,一次怀2个孩子,可以吗?
答:不建议一次怀孕2个孩子,因多胎妊娠本身就是一个危险因素,系统性血管炎属于风湿病中比较严重的类型,易出现或加重妊娠期间的合并症,导致妊娠失败或系统性血管炎的加重。
85.系统性血管炎患者如何选择分娩方式?
答:根据病情严重程度及产科指征共同决定。
1)妊娠满37周后,若病情稳定或轻度活动且无阴道分娩禁忌和并发症者,可在风湿免疫科及产科共同监控下,选择自然分娩。
2)当妊娠37周前出现疾病活动及产科并发症时,应全面评估疾病活动程度和胎儿情况,根据病情增加激素用量,如病情能获得有效控制,则可在密切监测下尽量延长孕周,当大剂量激素治疗仍难以控制病情或需加免疫*制剂抑**时,可及时终止妊娠,放宽剖宫产指征,选剖宫产。
3)当发生系统性血管炎重度活动而妊娠周数尚早且胎儿存活可能性很小时,应以治疗母体疾病为主(如放弃胎儿),可考虑在病情稳定后引产,经阴道引产。

86.系统性血管炎患者什么情况下应终止妊娠?
答:1)孕早期(妊娠前三个月)即出现明显的病情活动;
2)病情严重已经危及母体安全时,无论孕期大小都应该尽早终止妊娠;
3)孕期检测发现胎盘功能低下,危及胎儿的健康,经产科与风湿科治疗后无好转者;
4)妊娠满38周,胎儿发育成熟者,建议终止妊娠。
87.系统性血管炎患者终止妊娠时激素该如何使用?
答:1)口服强的松剂量在5mg/日以下者,且使用时间不超过1个月,围手术期不需要增加激素剂量 ;
2)如果强的松的剂量5mg/日以上,且使用时间超过1个月者,手术期间需要补充激素治疗。正常自然分娩、人工流产或中期引产手术,在手术当日加用强的松10~20mg或术前半小时静脉注射甲泼尼龙 20mg,手术次日恢复原口服剂量即可;
3)如果是剖宫产手术,在原口服剂量的基础上,手术当日和次日增加静脉注射甲泼尼龙20~40mg,手术第三日恢复至术前剂量。
88.系统性血管炎患者产后如何管理?
答:1)根据病情,及时调整肾上腺皮质激素、免疫*制剂抑**、低分子肝素等药物的剂量,对于有易栓倾向者,由于疾病发作和血栓的高风险,分娩后2~3个月要严密监护。
2)所有的患者都应行静脉血栓栓塞的风险评估,并在产后进行有效预防,且由于产后本身处于高凝状态,建议短期使用低分子肝素。
89.系统性血管炎患者是否可母乳喂养?
答:1)最好不要母乳喂养:主要原因是母乳喂养很辛苦,常夜间得不到休息,可能导致血管炎的病情复发,当然,长期病情稳定者,产后也可母乳喂养,注意预防疾病活动;
2)回奶的方法是产后12h内开始,溴隐亭2.5mg口服, 每日2次,连续14天。
3)如坚持要母乳喂养,则应多休息,维持硫酸羟氯喹、低剂量强的松或甲泼尼龙,如果强的松>20mg/日,则在服药4h后哺乳。
90.系统性血管炎哺乳期禁用的药物有哪些?
答:根据2020年美国风湿病学会指南,强烈建议母乳喂养时不用环磷酰胺、来氟米特、吗替麦考酚酯和沙利度胺;有条件地建议母乳喂养时不用甲氨蝶呤。
91.系统性血管炎患者哺乳期可用哪些药物?
答:1)部分非甾类抗炎药如布洛芬,双氯芬酸,酮基布洛芬,氟比洛芬,但有明显新生儿黄疸者不用。
2)泼尼松、甲泼尼龙或泼尼松龙:泼尼松剂量>20mg/d时,应待服药4h后哺乳。
3)硫酸羟氯喹。
92.哺乳期为什么使用泼尼松20mg/d以上,要间隔4小时才能哺乳?
答:激素可由乳汁微量分泌,乳汁浓度大约是血浆浓度的5%~25%,经乳汁摄入的药量<0.1%的母体剂量,不足婴儿内源性激素分泌量的10%,故一般来说,服用小剂量激素治疗是妇女哺乳是安全的,大剂量激素不建议母乳喂养,中等剂量的激素每天超过20mg,由于药物半衰期的原因,建议患者在用药4小时后哺乳相对安全,4小时前的乳汁弃去。

93.系统性血管炎患者孕期用免疫*制剂抑**对儿童免疫系统有何影响?
答:妊娠期用免疫*制剂抑**对儿童免疫系统无明显影响。多项研究发现,妊娠期用环孢素、硫唑嘌呤、硫酸羟氯喹、糖皮质激素(泼尼松、甲泼尼龙、地塞米松),大部分患者用至分娩,出生后平均随访一年,儿童的血常规、免疫球蛋白、淋巴细胞亚群、自身免疫抗体和感染发生率均与普通儿童无显著差异。
94.系统性血管炎患者孕中晚期(孕12周后)用免疫*制剂抑**对孩子出生有何影响呢?
答:见表17。

95.系统性血管炎患者孕期用他克莫司和抗TNFα生物制剂等,孩子可打疫苗吗?
答:1)孕期用抗TNFα生物制剂者:2020年出版的欧洲风湿病联盟指南提出,在妊娠后半期用抗TNFα生物制剂的患者,其新生儿在出生6个月内不应接种活疫苗,而在妊娠22周之前使用生物制剂,其新生儿可正常接种各种疫苗,包括活疫苗;尽管有研究资料提示,培塞利珠单抗在妊娠晚期不会透过胎盘屏障,但目前仍没有文献报道使用该药的孕妇分娩后的新生儿可接种活疫苗,因此需要慎重。
2)免疫*制剂抑**:只有比较明确的研究表明,孕期用硫唑嘌呤不影响儿童按计划接种疫苗,其他如糖皮质激素(泼尼松、甲泼尼龙、地塞米松等)、硫酸羟氯喹、环孢素或他克莫司等至今无大规模研究报道,但是根据临床经验,未发现上述药物会导致儿童注射疫苗的风险增加。研究表明,妊娠期用泼尼松+硫唑嘌呤+他克莫司或环孢素治疗的肾移植患者,孩子出生后按计划接种轮状病毒疫苗(活疫苗),在接种后2个月和4个月随访,不良反应发生率与普通儿童无显著差异;妊娠期使用环孢素、硫唑嘌呤、硫酸羟氯喹、地塞米松的自身免疫病患者,孩子出生后按计划接种乙肝疫苗和破伤风疫苗,疫苗的效果(乙肝表面抗体水平、抗破伤风IgG水平)和不良反应发生率与普通儿童均无显著差异。

致 谢
2020年春节后,我们陆续推出了《免疫性不良妊娠答疑解惑》系列专题,受到了广大患者和同行的好评,在此,对已参与该专题撰写、编辑、修改和补充的医生、专家和教授(见如下名单)表示深深的感谢!
众所周知,复发性不良妊娠的诊疗涉及面很广,不是哪一个医学专业所能完全覆盖的,每个医学专业的大夫观点和意见不尽相同,甚至完全相反,而广大的患友们更是非常迷惑、焦虑、痛苦甚至绝望,无所适从。为此,我们收集了数十场患者教育会过程中,患友们常提到或较关注的问题,组织全国相应专业的博士、高年资医生、专家和教授,以提问关键词相关内容的方式,进行了详细客观的回答,希望能对每一位有不良妊娠史孕妈妈的顺利怀孕和分娩有所帮助!
值得注意的是,《免疫性不良妊娠答疑解惑》系列专题内容是每一位医学工作者通过查阅国内外的文献资料,并结合自己的临床实践总结出来的,不一定适合于所有的患者,每一位患者应根据自身情况来综合分析和判断,这些资料仅供参考!
当然,在撰写、编辑、修改和补充过程中,肯定仍有不少的遗漏和错误,希望广大的读者们批评指正,我们将在出版书籍时予以纠正,谢谢!
刘湘源及其团队 2020-4-29
医学博士、医生、专和教授名单
(已网络发布,按姓氏拼音排序)
